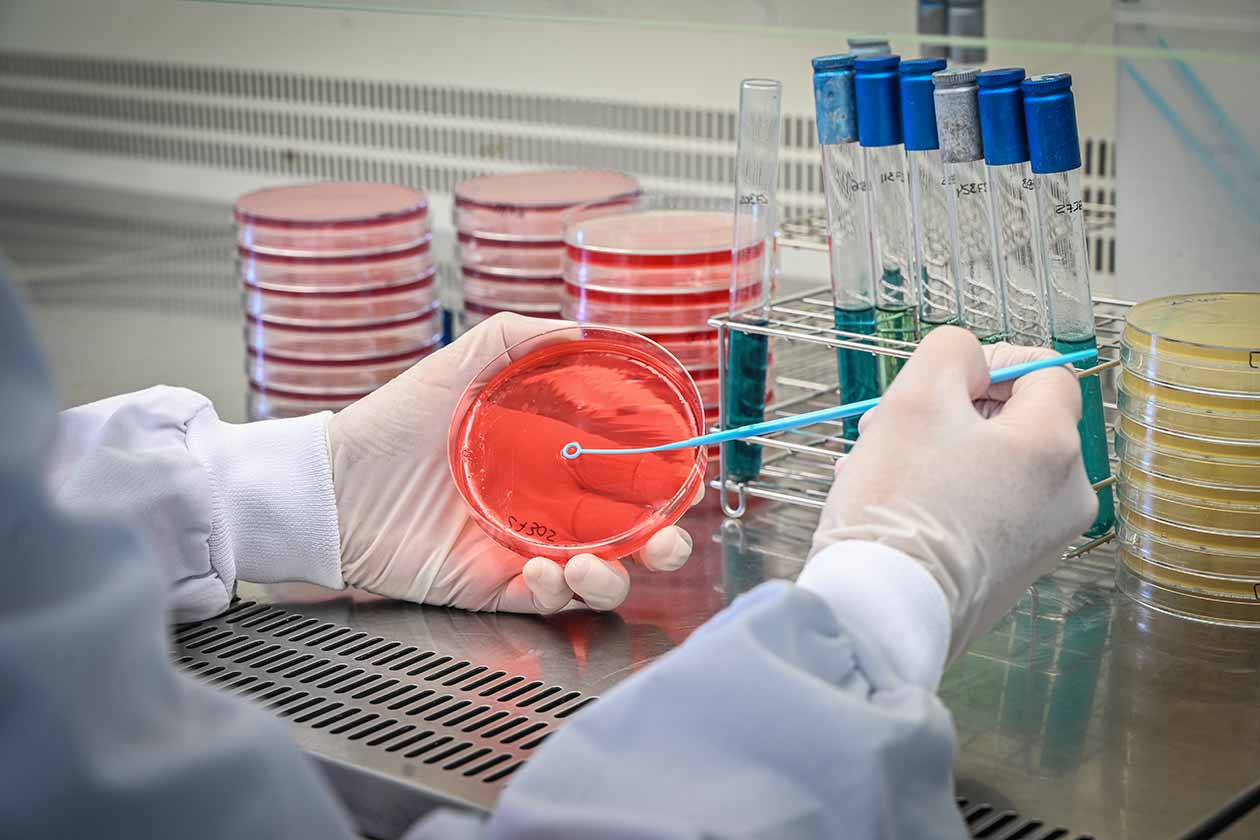

Las nuevas tendencias alimentarias inducen cambios en los productos que compramos, pero también en sus procedencias y formas de preparación. Desde el punto de vista de la seguridad alimentaria esto plantea nuevos retos que requieren adaptar los niveles de higiene a nuevas exigencias. Y para comprobar la inocuidad de los productos durante su periodo de vida hay que adaptar las condiciones y tipología de los estudios de vida útil (EVU) a estas nuevas exigencias. Te lo explicamos con algún ejemplo.
Como planteamos en el enunciado, nuevas tendencias de consumo, nuevos alimentos o alimentos producidos o cocinados de formas distintas a las tradicionales requieren adaptar las condiciones de higiene de los productos y su estudio. Como resulta difícil explicar esta necesidad de forma completamente general, vamos a ilustrar con algún ejemplo, la tendencia crudívora y en especial el consumo de carne cruda o poco hecha.
Carnes crudas o poco cocinadas
Lo primero que nos preguntamos es hasta qué punto son seguras las carnes crudas o poco cocinadas. Las recomendaciones son de cocinar por encima de 65 grados las carnes enteras y por encima de 70 – 75 grados las picadas, en ambos casos durante más de dos minutos. Estos tiempos de cocinado son sin duda superiores incluso a lo que suelen recomendar los chefs para la carne y los productos cárnicos poco hechos, que es además como suelen recomendar muchos de ellos consumir carnes de vacuno, cerdo, e incluso productos a base de picadas como hamburguesas, con el fin de poder apreciar al máximo las características del producto.
Pero entonces ¿Cómo he de estudiar la seguridad de mis productos si estos van a servirse poco cocinados? ¿Qué clase de EVU o Challenge Test debo realizar? ¿Y en qué condiciones debo hacer las pruebas?
Diferentes productos, procesos, formas de distribución y cocinados requieren adaptar el tipo de EVU y sus condiciones específicamente a cada caso
Para poder dar respuesta a estas necesidades cambiantes y particulares de cada empresa y producto, e incluso forma de distribución y consumo (por ejemplo, si se que mi producto va a ser ofrecido por la restauración poco hecho), contamos con tres tipos básicos de estudios de EVU o Challenge Test, que denominamos:
- EVU ante alterantes o patógenos naturales (los que nos van a aparecer en el producto).
- Estabilidad microbiana mediante Challenge test, ante contaminación accidental de patógeno o alterante.
- Estudio de potencial crecimiento de listeria, realizado según normativa vigente.
EVU ante alterantes o patógenos naturales (los que nos van a aparecer en el producto)
Consiste en estudiar la evolución de la flora microbiana de riesgo, ya sea para la seguridad del producto o para el mantenimiento de sus características organolépticas. La flora estudiada es la naturalmente presente en el producto, es decir, no se inocula intencionadamente. Las condiciones seleccionadas deben garantizar ser igual o más exigentes que las que van a darse en la práctica durante la vida del producto.
Estabilidad microbiana mediante Challenge test, ante contaminación accidental de patógeno o alterante
Consiste en investigar la estabilidad del producto, evaluando la capacidad que muestran ciertos microorganismos patógenos o alterantes, intencionadamente inoculados en el producto, para crecer o sobrevivir bajo ciertas condiciones ambientales, realizando para ello, un seguimiento analítico de la evolución de dichos microorganismos durante un tiempo de conservación determinado. Puede completarse con el estudio de efectividad del tratamiento térmico aplicado en el punto de venta, frente a la destrucción de los microorganismos inoculados, en el caso de productos para vender en restauración.
Estudio de potencial crecimiento de listeria, realizado según normativa vigente
La evaluación del Potencial de crecimiento de L.monocytogenes se realiza mediante estudios Challenge Test con objeto de poder clasificar los alimentos en las dos categorías que establece el Reglamento (CE) 2073/2005, alimentos listos para consumo capaces de soportar el crecimiento de Listeria monocytogenes (Categoría 1.2) y alimentos listos para consumo incapaces de soportar el crecimiento de Listeria monocytogenes (Categoría 1.3).
Por otra parte, la realización de estos estudios permite conocer a las empresas productoras, la concentración final de Listeria monocytogenes a partir de los niveles detectados desde el momento de la fabricación y saber si va a cumplir el límite de 100 u.f.c./g a final de su vida útil, además de determinar cuál debe ser la concentración inicial del Listeria monocytogenes en el producto para respetar el límite de 100 u.f.c./g al final de la misma.
Contamos con una dilatada experiencia en estudios de vida útil en todo tipo de productos y podemos ayudarte a seleccionar el tipo de estudio que, al menor coste posible, cubra tus necesidades para poder asegurar la inocuidad de tus productos en las condiciones reales en las que va a ser consumido, definir los límites de estas condiciones para que puedas darlas a conocer a tus clientes, y poder demostrar esto ante terceros, inspecciones, auditorias, etc. Si tienes dudas sobre los EVU que necesitas, ponte en nuestras manos, te daremos la mejor solución sin duda.